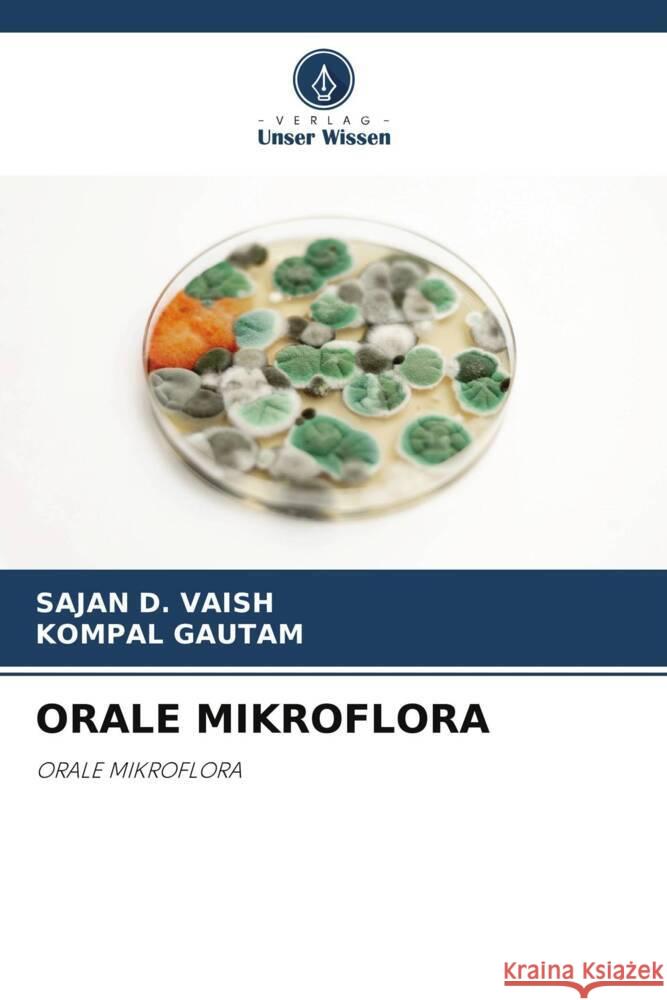
ORALE MIKROFLORA VAISH, SAJAN D., GAUTAM, KOMPAL 9786208220457 Verlag Unser Wissen
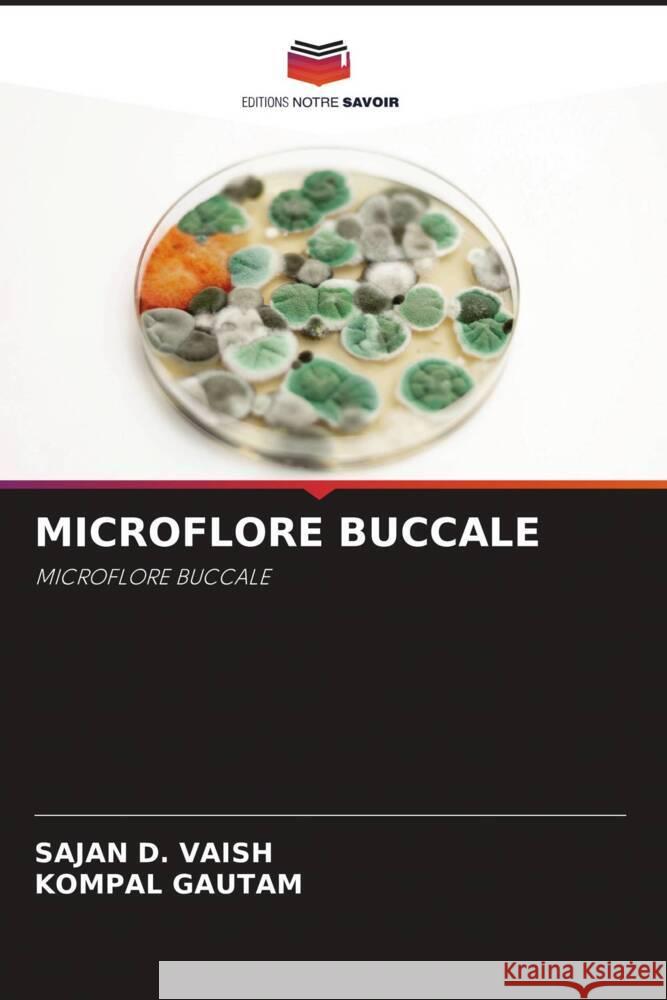
MICROFLORE BUCCALE VAISH, SAJAN D., GAUTAM, KOMPAL 9786208220525 Editions Notre Savoir
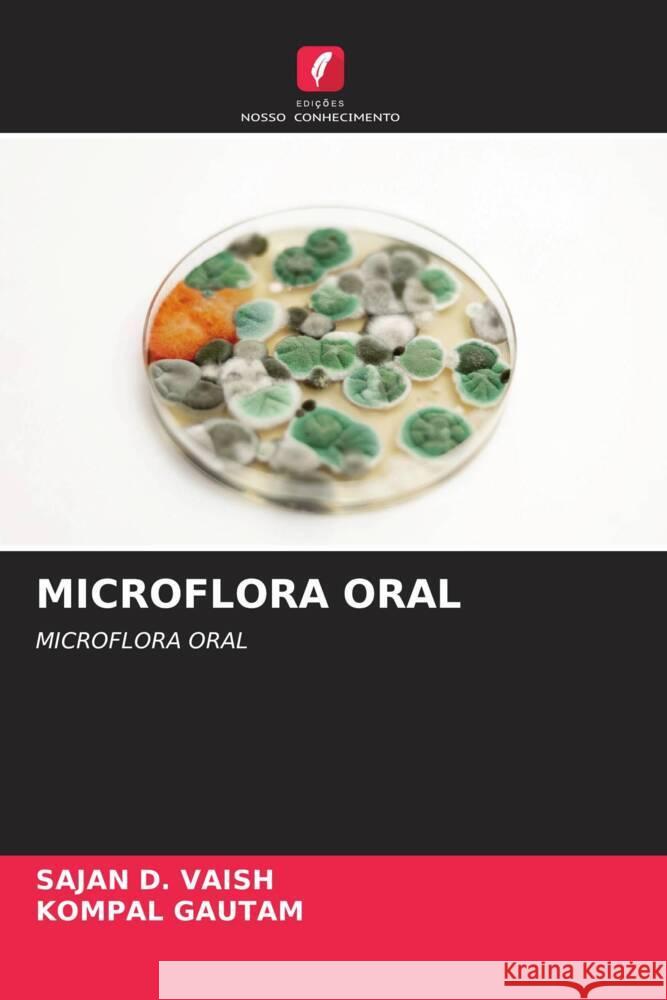
MICROFLORA ORAL VAISH, SAJAN D., GAUTAM, KOMPAL 9786208220556 Edições Nosso Conhecimento

» książki » Medical - Dentistry - General
 |
Pulpotomy: Techniques and Outcomes
ISBN: 9786207483976 / Angielski / Miękka / 108 str. Termin realizacji zamówienia: ok. 5-8 dni roboczych. This book focuses on the common procedure of pulpotomy in primary molars with extensive caries but no radicular pathology. It details the procedure of covering pulp stumps with pulp-capping agents to promote healing or fix underlying tissue. Throughout history, various pulpotomy agents have been utilized, including formaldehyde-based materials, electrosurgery, lasers, glutaraldehyde, haemostatic medicaments, zinc oxide eugenol, bone morphogenic protein (BMP), collagen, and calcium-inducing dentine bridge materials. This comprehensive exploration provides insights into the evolution and...
This book focuses on the common procedure of pulpotomy in primary molars with extensive caries but no radicular pathology. It details the procedure of...
|
cena:
272,40 |
 |
CAD CAM IN FPD
ISBN: 9786208237387 / Niemiecki / Miękka / 88 str. Termin realizacji zamówienia: ok. 5-8 dni roboczych. Die CAD/CAM-Technologie (Computer-Aided Design/Computer-Aided Manufacturing) hat die Herstellung von festsitzendem Zahnersatz (Fixed Partial Dentures - FPDs) verändert. Der Prozess umfasst das digitale Design und das präzise Fräsen der prothetischen Komponenten, wodurch die Genauigkeit, die Effizienz und die Ergebnisse für den Patienten erheblich verbessert werden.CAD/CAM hat das Design, die Produktion und die Lieferung von FPDs revolutioniert und bietet Vorteile bei der Präzision, den Materialoptionen, der Zeitersparnis und der allgemeinen Patientenerfahrung.
Die CAD/CAM-Technologie (Computer-Aided Design/Computer-Aided Manufacturing) hat die Herstellung von festsitzendem Zahnersatz (Fixed Partial Dentures ...
|
cena:
272,40 |
 |
BOGENDRÄHTE IN DER KIEFERORTHOPÄDIE
ISBN: 9786208248086 / Niemiecki / Miękka / 96 str. Termin realizacji zamówienia: ok. 5-8 dni roboczych. Dieses Buch befasst sich eingehend mit den Bögen, einschließlich ihrer Form, ihres Materials und ihrer Eigenschaften, sowie mit der Frage, wie diese Faktoren das Behandlungsergebnis beeinflussen.Die Entwicklung eines effektiven kieferorthopädischen Kraftsystems erfordert Kenntnisse über Mechanik, Biomaterialien und deren Zusammenspiel. Der ideale Bogendraht sollte so konzipiert sein, dass er die Zähne mit leichten, kontinuierlichen Kräften bewegt und sich über einen Zeitraum von Wochen bis Monaten elastisch verhält.Der Erfolg oder Misserfolg vieler Behandlungsformen hängt von der...
Dieses Buch befasst sich eingehend mit den Bögen, einschließlich ihrer Form, ihres Materials und ihrer Eigenschaften, sowie mit der Frage, wie diese...
|
cena:
272,40 |
|
ORALE MIKROFLORA
ISBN: 9786208220457 / Niemiecki / Miękka / 84 str. Termin realizacji zamówienia: ok. 5-8 dni roboczych. Die Mundhöhle ist eines der komplexesten mikrobiellen Habitate. Im menschlichen Körper bezieht sich die Terminologie, die zur Beschreibung von Mikroorganismen in der Mundhöhle verwendet wird, auf die orale Mikroflora. In Zukunft könnte es möglich sein, die Behandlung gezielter auf bestimmte Krankheitserreger auszurichten, oder es könnten einfallsreichere Ansätze zur Vorbeugung von Krankheiten eingesetzt werden. In diesem Zusammenhang wird das Ergebnis der aktuellen klinischen Studie mit Bakteriocin-produzierenden nicht säurebildenden, aber leicht konkurrierenden Stämmen von S. Mutans...
Die Mundhöhle ist eines der komplexesten mikrobiellen Habitate. Im menschlichen Körper bezieht sich die Terminologie, die zur Beschreibung von Mikro...
|
cena:
272,40 |
 |
INTRAORALSCANNER
ISBN: 9786208219024 / Niemiecki / Miękka / 100 str. Termin realizacji zamówienia: ok. 5-8 dni roboczych. Ein intraoraler Scanner ist ein tragbares Gerät, mit dem direkt digitale Abdruckdaten der Mundhöhle erstellt werden. Die Scansoftware interpretiert die Daten, um ein Echtzeit-3D-Modell zu erstellen, das auf einem Touchscreen angezeigt wird, indem Licht auf Scan-Objekte, wie z. B. komplette Zahnbögen, projiziert wird. Auf diese Weise entstehen qualitativ hochwertige Fotos mit genauen Details des Hart- und Weichgewebes des Mundes.Diese intraoralen Scanner arbeiten mit nicht-invasiven optischen Technologien wie konfokaler Mikroskopie, Lichttriangulation und aktiver Abtastwellenfront, die...
Ein intraoraler Scanner ist ein tragbares Gerät, mit dem direkt digitale Abdruckdaten der Mundhöhle erstellt werden. Die Scansoftware interpretiert ...
|
cena:
272,40 |
 |
REGENERATIVE ENDODONTICS
ISBN: 9786208224844 / Angielski / Miękka / 128 str. Termin realizacji zamówienia: ok. 5-8 dni roboczych. Pulpal and peri radicular pathosis, which can be caused by caries, trauma, or dental abnormalities, is a common disease in clinic for dental treatment. Root canal treatment (RCT) is a conventional option to manage the endodontic diseases in fully developed permanent teeth demonstrating outstanding clinical outcomes, while apexification procedure is the traditional treatment modality for the immature permanent teeth with pulp necrosis. However, these treatment procedures remove the pulp and some dentin tissues, which weaken the dentinal strength, immunological responses and proprioceptive...
Pulpal and peri radicular pathosis, which can be caused by caries, trauma, or dental abnormalities, is a common disease in clinic for dental treatment...
|
cena:
272,40 |
 |
Zysten und Tumore in der Kinderzahnheilkunde
ISBN: 9786208220273 / Niemiecki / Miękka / 68 str. Termin realizacji zamówienia: ok. 5-8 dni roboczych. Pathologien der Mundhöhle sind ein wichtiger Schwerpunkt für Kinderzahnärzte - sie treten als einzigartige Symptome mit unterschiedlicher Häufigkeit auf. Viele orale Läsionen, die in den ersten Lebensjahren auftreten, können schwächend sein und die Ernährung und damit das Wachstum des Kindes beeinträchtigen. Die Kenntnis solcher Läsionen ist wichtig, um den Kinderarzt und den Kinderzahnarzt zu den richtigen Behandlungsmöglichkeiten anzuleiten. Dieses Buch ist eine kurze und prägnante Sammlung von häufigen Zysten und Tumoren in der Mundhöhle von Kindern. Es bietet eine umfassende...
Pathologien der Mundhöhle sind ein wichtiger Schwerpunkt für Kinderzahnärzte - sie treten als einzigartige Symptome mit unterschiedlicher Häufigke...
|
cena:
272,40 |
 |
MICROFLORA ORALE
ISBN: 9786208220532 / Włoski / Miękka / 80 str. Termin realizacji zamówienia: ok. 5-8 dni roboczych. |
cena:
272,40 |
 |
SCANNERS INTRA-ORAIS
ISBN: 9786208219185 / Portugalski / Miękka / 100 str. Termin realizacji zamówienia: ok. 5-8 dni roboczych. |
cena:
272,40 |
 |
Cisti e tumori in odontoiatria pediatrica
ISBN: 9786208220303 / Włoski / Miękka / 68 str. Termin realizacji zamówienia: ok. 5-8 dni roboczych. |
cena:
272,40 |
|
MICROFLORE BUCCALE
ISBN: 9786208220525 / Francuski / Miękka / 80 str. Termin realizacji zamówienia: ok. 5-8 dni roboczych. La cavité buccale est l'un des habitats microbiens les plus complexes. Dans le corps humain, la terminologie utilisée pour décrire les micro-organismes de la cavité buccale fait référence à la microflore buccale. À l'avenir, il sera peut-être possible de cibler le traitement plus spécifiquement sur des agents pathogènes particuliers ou d'utiliser des approches plus imaginatives pour prévenir les maladies. Dans ce contexte, les résultats de l'essai clinique actuel avec des souches de S. Mutans produisant des bactériocines, non acidogènes mais faiblement compétitives, seront...
La cavité buccale est l'un des habitats microbiens les plus complexes. Dans le corps humain, la terminologie utilisée pour décrire les micro-organi...
|
cena:
272,40 |
 |
SCANNERS INTRA-ORAUX
ISBN: 9786208219109 / Francuski / Miękka / 100 str. Termin realizacji zamówienia: ok. 5-8 dni roboczych. Un scanner intra-oral est un appareil portable utilisé pour créer directement des empreintes numériques de la cavité buccale. Le logiciel de numérisation interprète les données pour construire un modèle 3D en temps réel qui est affiché sur un écran tactile en projetant de la lumière sur les objets numérisés, tels que des arcades dentaires complètes. Il en résulte des photos de haute qualité avec des détails précis des tissus durs et mous de la bouche.Ces scanners intra-oraux utilisent des technologies optiques non invasives telles que la microscopie confocale, la...
Un scanner intra-oral est un appareil portable utilisé pour créer directement des empreintes numériques de la cavité buccale. Le logiciel de numé...
|
cena:
272,40 |
 |
Kystes et tumeurs en odontologie pédiatrique
ISBN: 9786208220297 / Francuski / Miękka / 72 str. Termin realizacji zamówienia: ok. 5-8 dni roboczych. Les pathologies de la cavité buccale constituent un domaine d'intérêt important pour les dentistes pédiatriques - elles se présentent sous la forme de symptômes uniques avec une fréquence variable. De nombreuses lésions buccales observées dans les premières années de la vie peuvent être débilitantes et affecter la nutrition et donc la croissance de l'enfant. Il est important de se familiariser avec ces lésions pour guider le pédiatre et le dentiste pédiatrique vers des options de prise en charge appropriées. Ce livre est une collection brève et concise de kystes et de...
Les pathologies de la cavité buccale constituent un domaine d'intérêt important pour les dentistes pédiatriques - elles se présentent sous la for...
|
cena:
272,40 |
 |
Role of Medical History in Prosthetic Treatment
ISBN: 9786208117023 / Angielski / Miękka / 128 str. Termin realizacji zamówienia: ok. 5-8 dni roboczych. Medical history is a foundational element in dental prosthodontics, profoundly impacting treatment planning, material selection, and procedural strategies. A comprehensive understanding of a patient's medical background is essential for tailoring dental care to meet individual needs while mitigating risks. Systemic health conditions such as diabetes, cardiovascular disease, osteoporosis, and autoimmune disorders can significantly influence the choice of prosthetic materials, the timing of procedures, and the overall approach to treatment.For example, diabetes may affect wound healing,...
Medical history is a foundational element in dental prosthodontics, profoundly impacting treatment planning, material selection, and procedural strate...
|
cena:
272,40 |
|
MICROFLORA ORAL
ISBN: 9786208220556 / Portugalski / Miękka / 80 str. Termin realizacji zamówienia: ok. 5-8 dni roboczych. |
cena:
272,40 |
 |
Sélection de teintes en dentisterie esthétique
ISBN: 9786208285821 / Francuski / Miękka / 92 str. Termin realizacji zamówienia: ok. 5-8 dni roboczych. "Sélection de teintes en dentisterie esthétique" explore le processus complexe de sélection de teintes dentaires, un aspect essentiel de la dentisterie restauratrice axée sur l'obtention de restaurations dentaires d'apparence naturelle. Les méthodes visuelles traditionnelles, telles que l'utilisation de guides de teintes, conduisaient souvent à des résultats incohérents en raison d'influences subjectives telles que l'éclairage, l'expérience de l'observateur et des facteurs environnementaux. Pour surmonter ces défis, les progrès modernes tels que les spectrophotomètres et...
"Sélection de teintes en dentisterie esthétique" explore le processus complexe de sélection de teintes dentaires, un aspect essentiel de la dentist...
|
cena:
272,40 |
 |
Accelerators In Orthodontics
ISBN: 9786139455720 / Angielski Termin realizacji zamówienia: ok. 5-8 dni roboczych. |
cena:
272,40 |
 |
M?decine parodontale
ISBN: 9786203017014 / Francuski Termin realizacji zamówienia: ok. 5-8 dni roboczych. |
cena:
272,40 |
 |
Medicina parodontale
ISBN: 9786203171723 / Włoski Termin realizacji zamówienia: ok. 5-8 dni roboczych. |
cena:
272,40 |
 |
Die Rolle der konservierenden Zahnheilkunde und der Endodontie in der forensischen Odontologie
ISBN: 9786203356465 / Niemiecki Termin realizacji zamówienia: ok. 5-8 dni roboczych. |
cena:
272,40 |













